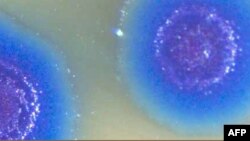
Геном за тысячу долларов

Секвенатор Ion Proton компании Ion Torrent построен на чипах CMOS, тех же самых, что используются в цифровых камерах. В приборе Ion Proton эти чипы регистрируют не свет, как в фотографии, а то, как молекулы ДНК из раствора и закрепленные на чипе пробные молекулы ДНК соединяются друг с другом. Если их последовательности полностью соответствуют друг другу, сигнал получается одним. Когда между двумя молекулами ДНК существуют несовпадения в последовательности, сигнал отличается. Повышение скорости чтения и удешевление чипов происходило по обычным для микроэлектроники сценариям. Гонка шла за увеличением плотности сенсоров и их точностью. Теперь, когда сделаны крупные успехи на этом пути, можно ожидать дальнейшего повышения точности и снижения цены. Компания Ion Torrent уже сейчас объявляет о следующем чипе Ion Proton II, у которого будет 660 миллионов сенсоров против 165 миллионов на заявленном на этой неделе чипе Ion Proton I. Стоимость секвенатора Ion Torrent 149 тысяч долларов.
Непосредственный конкурент Ion Torrent – компания Illumina (www.illumina.com) также объявила секвенатор для генома за тысячу долларов. Сам прибор стоит значительно дороже – свыше $500,000. При стоимости одного генома в тысячу долларов, эта машина работает гораздо быстрее Ion Proton. Скорость считывания у нее в 120 раз выше, и, соответственно, она может считать геном буквально за минуты. Кроме того, Illumina заявила о создании менее быстрой машины в той же ценовой категории, что и Ion Proton, однако и этот аппарат быстрее в 7 раз. Illumina использует для чтения генома иную технологию: ее сенсоры представляют собой световую камеру, которая регистрирует флюоресценцию от молекул ДНК с меткой. Эти молекулы «садятся» на молекуле на чипе. По уровню флюоресценции после связывания можно сказать, насколько точно их последовательности совпадают.
Характерная деталь: компания Ion Torrent избрала шоу бытовой электроники, проходящее в Лос Анджелесе, чтобы заявить о своей новой машине. Это говорит кое-что о предполагаемых клиентах. Диапазон цен на лабораторные исследования в США начинается от сотен долларов. Многие лабораторные исследования стоят около тысячи долларов, например типичное сканирование MRI может обойтись от 400 до 3500 долларов. Таким образом, индивидуальный геном вошел в диапазон цен, которые американцы обычно тратят на медицинские услуги. Рентгеновские снимки и трехмерные сканы дают понятную информацию: они позволяют увидеть состояние тканей человека под кожным покровом. А что можно сказать, прочитав геном человека? С одной стороны – очень многое. Геном человека это информация о наследственных заболеваниях, которым он может быть подвержен, об особенностях его физиологии, переносимости лекарств и даже, в значительной степени – о его темпераменте. Но это информация лишь об особенностях и предрасположенностях, а не о конкретном заболевании или состоянии здоровья. И в этом смысле индивидуальный геном говорит не так уж много. Речь идет в основном о данных для превентивной медицины. С их помощью можно корректировать образ жизни, диету, физические нагрузки, чтобы избежать определенных заболеваний в будущем. Но в рамках сложившейся системы здравоохранения в США, в которой доминируют страховочные компании, превентивная медицина находится на обочине. Ее роль невелика, и фактически она сводится к программам предотвращения всего нескольких заболеваний и к плохо финансируемой альтернативной медицине.
Другой потенциальной сферой применения дешевых геномов выступают те самые страховочные компании. Для них выгода оценки рисков очевидна. Если сумма страховки надежно увязана с реальным риском, их прибыли вырастут. Но на этом пути стоят не только технологические барьеры. Чтобы увязать страховочные выплаты с генетикой человека, нужно выделять отдельные группы населения и фактически облагать их различным налогом на медицину. Законность подобных практик под большим вопросом в обществе, декларирующем равенство возможностей для всех.